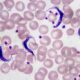
¿Qué causa la tripanosomiasis africana?

Las habilidades básicas para tomar decisiones son fundamentales en el proceso de resolución de problemas, especialmente en contextos que requieren intervención o juicio, como en el ámbito médico. Cada uno de estos componentes es esencial para tomar decisiones informadas, equilibradas y apropiadas, ya que se basan en la capacidad del individuo para analizar, comprender, valorar y comunicar opciones de manera adecuada. A continuación, se detallan estas habilidades en su conjunto, comenzando por la capacidad de expresar una elección, luego la comprensión de la información, la apreciación de la situación, y finalmente el razonamiento lógico que lleva a una conclusión.
Expresión de una elección: Este es el primer y más elemental paso en el proceso de toma de decisiones. Implica la capacidad de manifestar una preferencia o decisión de manera clara y comprensible. Esta expresión puede realizarse mediante diversos medios, tales como el lenguaje verbal, escrito o a través de gestos. En un contexto médico, por ejemplo, un paciente puede necesitar expresar su elección sobre un tratamiento a seguir, un procedimiento o una opción entre diversas alternativas terapéuticas. La claridad en esta expresión es esencial, ya que permite a los profesionales de la salud conocer las intenciones del paciente y considerar sus deseos al tomar decisiones en conjunto. Este paso requiere de una capacidad de comunicación efectiva, ya que una decisión mal expresada o mal entendida puede llevar a malentendidos o a la implementación de soluciones inapropiadas.
Comprensión: La habilidad para comprender la información relevante para la toma de decisiones es crucial, ya que sin una adecuada comprensión, el proceso de decisión pierde eficacia. Comprender implica no solo recibir la información, sino también ser capaz de interpretarla en su contexto y reconocer sus implicaciones. En el caso de decisiones médicas, esto significa entender el diagnóstico, las opciones de tratamiento, los riesgos asociados a cada opción y las consecuencias de las decisiones tomadas. La comprensión también involucra la capacidad de reconocer qué información es esencial y qué detalles adicionales pueden ser irrelevantes o secundarias. Una comprensión deficiente de la información puede llevar a decisiones erróneas o subóptimas, especialmente si se omiten detalles críticos relacionados con la enfermedad del paciente o el tratamiento propuesto.
Apreciación: La apreciación se refiere a la habilidad de valorar la importancia y el impacto de una situación en particular, tomando en cuenta todos los factores relevantes. En un contexto clínico, esto implica valorar adecuadamente la enfermedad que padece un paciente en su situación concreta, así como las implicaciones de esa enfermedad sobre su vida y bienestar. Apreciar la gravedad de una enfermedad, la urgencia de una intervención o las necesidades específicas del paciente es esencial para priorizar adecuadamente las decisiones. La apreciación también requiere un enfoque empático, ya que se debe considerar no solo el estado físico del paciente, sino también sus emociones, deseos y circunstancias personales. Una apreciación adecuada permite al tomador de decisiones ponderar las alternativas de manera equitativa y justa, reconociendo la relevancia de las necesidades inmediatas y a largo plazo.
Razonamiento: El razonamiento es el proceso mediante el cual se desarrollan sistemas lógicos y argumentaciones basadas en la información comprendida y apreciada. Este paso implica analizar las diferentes opciones disponibles, evaluar sus posibles consecuencias y desarrollar una conclusión razonada que guíe la elección final. En el contexto médico, el razonamiento implica integrar datos clínicos, el historial del paciente, las expectativas de tratamiento y los resultados posibles para determinar la mejor opción para el paciente en su situación específica. El razonamiento efectivo es fundamental para evitar decisiones impulsivas o sin fundamento y garantizar que las decisiones se basen en una lógica sólida. Para que este razonamiento sea válido, debe ser reflexivo y considerar todos los factores relevantes, eliminando cualquier sesgo que pueda distorsionar el juicio.
En conjunto, estas habilidades forman la base de un proceso de toma de decisiones efectivo, ya que permiten a los individuos, ya sean pacientes o profesionales de la salud, expresar sus opciones, comprender la información disponible, valorar correctamente la situación y razonar de manera lógica hacia la mejor solución posible. Cada una de estas habilidades se complementa y refuerza mutuamente, de modo que el proceso de toma de decisiones se vuelve un acto reflexivo, informado y éticamente fundamentado.


Fuente y lecturas recomendadas:
- Goldman, L., & Schafer, A. I. (Eds.). (2020). Goldman-Cecil Medicine (26th ed.). Elsevier.
- Loscalzo, J., Fauci, A. S., Kasper, D. L., Hauser, S. L., Longo, D. L., & Jameson, J. L. (Eds.). (2022). Harrison. Principios de medicina interna (21.ª ed.). McGraw-Hill Education.
- Papadakis, M. A., McPhee, S. J., Rabow, M. W., & McQuaid, K. R. (Eds.). (2024). Diagnóstico clínico y tratamiento 2025. McGraw Hill.
- Rozman, C., & Cardellach López, F. (Eds.). (2024). Medicina interna (20.ª ed.). Elsevier España.